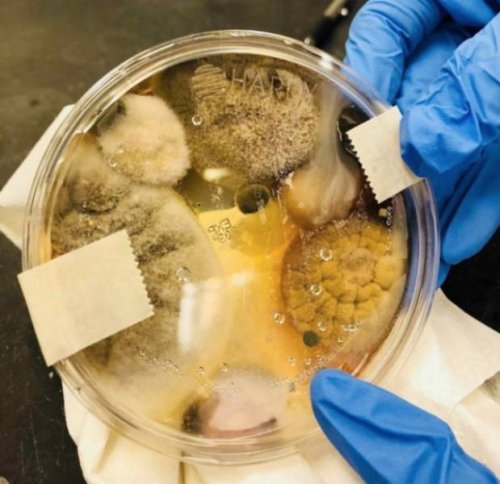

1. Несколько из 19 собак-терапевтов из группы LCC K-9 Comfort Dogs, которые в настоящее время находятся в Паркленде (Parkland), штат Флорида, чтобы оказывать поддержку людям

2. Целая команда ученых работала над тем, чтобы восстановить лицо девушки-подростка, используя найденный в Греции 9000 - летний череп

Встречайте Дон, девушку-подростка из Мезолита, которая жила около 7000 лет до н. э. Ее лицо было реконструировано учеными с помощью черепа, обнаруженного в 1993 году.
Основываясь на анализе костей и зубов, Дон было от 15 до 18 лет. У нее хмурое лицо, а челюсть выступает вперед. Исследователи полагают, что причина этого кроется в том, что девушка регулярно жевала шкуру животных, чтобы сделать ее мягкой кожей. Это не было ее хобби, а обычной для того времени практикой.
3. Вид из кабины пилота F16

4. Когда ты потерял в аварии большой палец руки, и его заменили на большой палец ноги

5. Руководство по астрономии 2018

6. «Я родилась с аномалией: большой палец на моей правой руке не может сгибаться»

7. Лапа спящего медведя гризли

8. Американские пожарные через границу тушат пожар в Мексике

9. «Моя сестра сделала тест на аллергию, и оказалось, что она страдает аллергией на все, на что ее проверяли»

10. Ледяные столбы в Канаде

11. Вихри на Юпитере

12. Этот пень похож на старый кусок хлеба

13. Моей девушке недавно сделали пересадку роговицы. Вот изображение высокого разрешения, на котором видны стежки в ее глазу.

14. DeepWorker 2000, подводная лодка на одного человека

15. Невероятное дерево в лесу

16. Ночной кошмар любого дантиста

17. Похоже, чья-то мечта сбылась, и из крана стало течь виски

18. Здоровый попугай против попугая с заболеванием перьев

19. Зубы тюленя-крабоеда

20. Очень странная квитанция с заправки

21. Маклюра оранжевая

22. Обледенелый велосипед после зимней бури в Чикаго

23. «Эту крошечную раковину морского ежа мой папа нашел в Калифорнии»

24. Выжившая после удара молнии

25. Симметричные кольца радуги

26. Дерево, растущее на вершине пня

27. Это замерзшее озеро выглядит как улица

28. Результаты в чаше Петри: 3 минуты в сушилке для рук
29. Это Соня Лесли (Sonya Leslie), она родилась с родинкой в глазу

30. Верблюжья стрижка




























